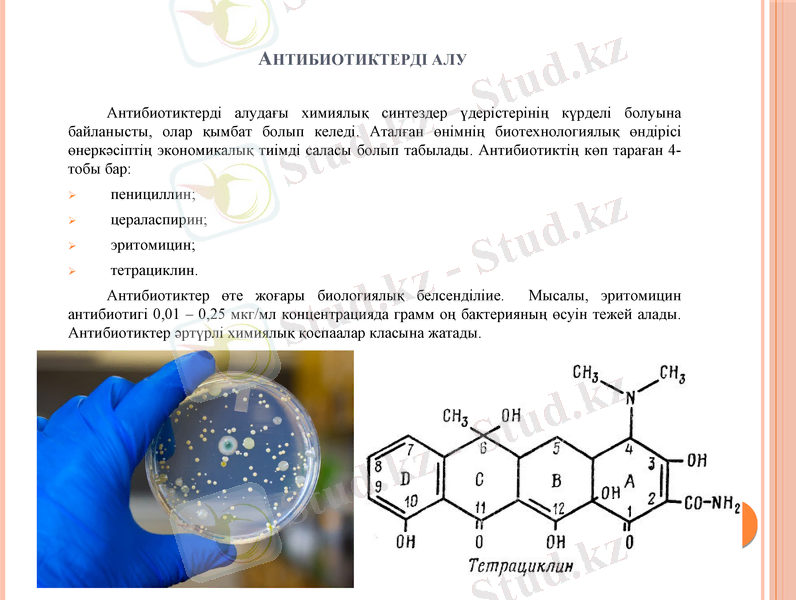
Slide 9

Екіншілік метаболиттердің биотехнологиясы



ҚАЗАҚСТАН РЕСПУБЛИКАСЫНЫҢ БІЛІМ ЖӘНЕ ҒЫЛЫМ МИНИСТРЛІГІ М. Х. ДУЛАТИ АТЫНДАҒЫ ТАРАЗ МЕМЛЕКЕТТІК УНИВЕРСИТЕТІ ТЕХНОЛОГИЯЛЫҚ ФАКУЛЬТЕТІ ТАМАҚ ӨНІМДЕРІ МЕН ҚАЙТА ӨҢДЕУ ӨНДІРІСТЕРІНІҢ ТЕХНОЛОГИЯСЫ ЖӘНЕ БИОТЕХНОЛОГИЯ КАФЕДРАСЫ
Тақырыбы:
Екіншілік метаболиттер алу биотехнологиясы
Орындаған: Келесбекова У. М
Қабылдаған: Қиябаева Ә. А
Курс:2
Тобы: В17БТЕХ-1, 3
Тараз 2019

Жоспары
КІРІСПЕ
НЕГІЗГІ БӨЛІМ
1. Екіншілік метаболиттер
2. Екіншілік метаболиттер жіктелуі
2. 1. Антибиотиктер
2. 2. Өсімдіктерден алынатын антибиотик
2. 3. Антибиотиктердің биологиялық шығу тегі
2. 4. Антибиотиктерді өнеркәсіптік өндіру технологиясы
ҚОРЫТЫНДЫ
ПАЙДАЛАНЫЛҒАН ӘДЕБИЕТТЕР ТІЗІМІ

КІРІСПЕ
Биотехнологиялық өндірістің өнімдері - табиғи макромолекулалар - өсімдіктер мен жануарлардың тіндері мен микроорганизмдерінің жасушаларынан оқшауланған ақуыздар, ферменттер, полисахаридтер, полиэфирлер. Өсімдік процестеріне байланысты тірі жасушалардың төмен молекулалық массадағы метаболизм өнімдері біріншілік және екіншілік метаболиттерге бөлінеді.
Біріншілік метаболиттер - микроорганизмдердің өсуі үшін қажетті молекулалық қосылыстар. Олардың кейбіреулері макромолекулалардың құрылымдық блоктарына жатады. Өнеркәсіптік маңызды метаболиттер арасында амин қышқылдар, органикалық қышқылдар, пурин және пиримидин нуклеотидтері, еріткіштер мен витамендер ерекшеленуі мүмкін.
Екіншілік метаболиттер таза молекуланың өсуі үшін қажет емес молекулярлық салмақты қосылыстар болып табылады. Екіншілік метаболиттерге антибиотиктер, алкалоидтар, өсімдіктердің өсу гормондары және токсиндер жатады

Екіншілік метаболиттер
Екінші реттік метаболиттер немесе идиолиттер - микроорганизмнің тіршілігіне, өсуіне қажетсіз төменгі молекулалық қосылыстар. Олар құрамы бойынша аз мөлшерде синтезделетін таксономиялық топтар және бір химиялық топқа жатаын жақын туысты қосылыстар қоспасы болып келеді. Екінші реттік метаболиттер синтездері кезінде микроорганизмдер бірінші тез өсу сатысынан (тропофаза) өтіп, кейін өсуінің бәсеңденуіне байланысты, идеофазаға ауысады. Осы идеофаза сатыларында идеолиттер түзіледі.
Екінші метаболиттерді алу принциптері микробтық жасушалар арқылы олардың пайда болу ерекшеліктеріне негізделген. Өсудің тежелу сатысында және стационарлық фазада кейбір микроорганизмдер логарифмдік фазада пайда болмайтын және метаболизмде айқын рөл атқармайтын заттарды синтездейді. Бұл заттар екіншілік метаболиттер деп аталады. Барлық микроорганизмдер оларды синтездейді, бірақ негізінен тамырлы бактериялар, саңырауқұлақтар және спора жасайтын бактериялар. Екінші метаболиттердің арасында антибиотиктер өндіру тұрғысынан жетекші орын алады.

Екіншілік метаболиттердің жіктелуі
Екіншілік метаболиттерге жатады:
Антибиотиктер;
Алкалоидтар;
Өсу гормондары;
Токсиндер

Антибиотик
Антибиотиктер класына зең саңырауқұлақтарына қарсы агенттер, ісікке қарсы дәрілер мен алкалоидтар жатады. 1945 жылы Кальари (Сардания) қаласындағы гигиена институтынан Бротзу деген ғалым теңіз суы сынамасынан антибиотиктер синтездей алатын Cephalosporium acremonium саңырауқұлақтарын тапты. Антибиотиктер ішіндегі цефалоспорин С, пеницилиндерге тұрақты грамм оң бактерияларға қарсы тиімділіктерін байқатқан.
Мұндай дәрмектер түріне және оның қолданылу мөлшеріне байланысты, бактерицидтік немесе бактериостатикалық әсер көрсетуі мүмкін. Бұлардың ішінде ең көп сұранысқа ие болғандары - пенициллин, цефалоспорин мен тетрациклиндер.
Антибиотиктер көбінесе микроорганизмдерден алынатын фармакологиялық препараттардың ең үлкен класы. Препараттың түріне және оны қолдану мөлшеріне байланысты олар бактерицидтік немесе бактериостатикалық әсер көрсетуі мүмкін. Бұл заттардың химиялық синтезінің күрделі болуына байланысты қымбат болып келеді. Антибиотиктердің биотехнологиялық өндірісі өнеркәсіптің экономикалық тиімді саласы болып табылады.

Өсімдіктерден алынатын антибиотик
Антибиотиктерді тек қана микроорганизмдер ғана емес, сонымен бірге өсімдіктер мен жануарлар жасушалары да синтездей алады. Өсімдіктерден алынатын антибиотиктер фитонциндер деп аталады Фитонцидтерді ең алғаш 1928 жылы Б. П. Токин ашқан болатын. Бұлардың қатарында сарымсақтан алынатын хлорелин, томатин, сативин және пияздан дайындалаттын алин фитонцидтерін атауға болады.
Б. П. Токин

Фитонцид бөлетін өсімдіктер
Құс шие (черёмуха)
Қарағай ағашы
Ақжелкек
Сарымсақ
пияз
Антибиотиктерді алу
Антибиотиктерді алудағы химиялық синтездер үдерістерінің күрделі болуына байланысты, олар қымбат болып келеді. Аталған өнімнің биотехнологиялық өндірісі өнеркәсіптің экономикалық тиімді саласы болып табылады. Антибиотиктің көп тараған 4-тобы бар:
пенициллин;
цераласпирин;
эритомицин;
тетрациклин.
Антибиотиктер өте жоғары биологиялық белсенділіие. Мысалы, эритомицин антибиотигі 0, 01 - 0, 25 мкг/мл концентрацияда грамм оң бактерияның өсуін тежей алады. Антибиотиктер әртүрлі химиялық қоспаалар класына жатады.

Антибиотиктердің биологиялық шығу тегі
Эубактерияға жататын микроорганиздер шығаратын антибиотиктер: пиоцианин - Pseudоmonas aeruginosa, вискозин - Ps. viscose, дипломицин, низин - Lactococcus lactis, продигиозин - Serratia marcescens, колиформин - Echerichia coli, протаптин - Proteus vulgaris;
Actinomycetales түріне жататын микроорганизмдер шығаратын антибиотиктер:
а) Streptomyces түріне жататын микроорганизмдер: стрептомицин - S. griseus, тетракцилин - S. aureofaciens, новобцин - S. spheroides, эритромицин - Saccharopolyspora erythraea, актиномицин - S. antibioticus;
ә) Nocardia түріне жатын микрорганизмдер: рифамицин - N. mediterranei, ристомицин -N. fructiferi;
б) Actinamodura түріне жататын микрорганизмдер: карминомицин - A. carminata
в) Micromonospora түріне жататын микрорганизмдер: фортимицины - M. olivoasterospora, гентамицины - M. purpurea ;
Цианобактериялар шығаратын антибиотиктер: малинголид - Lyngbya majuscula;
Жетілмеген саңырауқұлақтар өндіретін антибиотиктер: пенициллин - Penicillum chrysogenum, гризеофульвин - P. griseofulvum;
Лишайниктер, саңырауқұлақтар және төменгі сатыдағы өсімдіктер өндіретін антибиотиктер: хлореллин - Chiorella vulgaris ;
Жоғарғы сатыдағы өсімдіктер өндірітен антибиотиктер: аллицин- Alliium sativum, рафанин - Raphanus sativum;
Жануарлар өндіретін антибиотиктер: лизоцим, экмолин, круцин, интерферон.

Антибиотиктерді өнеркәсіптік өндірудің технологиясы
Антибиотиктердің биосинтезі, сондай-ақ кез-келген басқа екіншілік метаболиттер клеткалық популяцияның (трофофаздың соңы) баяу өсу фазасында өседі және стационарлық фазаға (идиофаза) жетеді. Трофофаздың соңында клеткалардың ферментативті күйі өзгереді, қайталама метаболизмнің индуцирлері қайталама метаболизм гендерін катаболикалық репрессияның әсерінен босатады. Сондықтан жасуша пролиферациясын және белсенді өсуін, стресстік жағдайларды тежейтін кез келген механизмдер антибиотиктердің пайда болуын белсендіреді.
Идиолиттерді өсіру процесі екі кезеңнен тұрады (екі сатылы өсіру) . Бірінші кезең - микроорганизмнің өсуі үшін ортада өсетін биомассаның жеткілікті мөлшерін жинақтау. Бұл фаза тез және қоректік орта арзан болуы керек. Екінші кезеңде антибиотикті іске қосу және белсенді синтезі жүргізіледі. Осы кезеңде ашыту өнімді ортада жүзеге асырылады.
Антибиотиктерді қалыптастыру микроорганизмдерді өсіру шарттарымен реттеледі. Сондықтан қоректік ортаны оңтайландыру өнімнің өнімділігін арттырудың негізгі факторы болып табылады.
- Іс жүргізу
- Автоматтандыру, Техника
- Алғашқы әскери дайындық
- Астрономия
- Ауыл шаруашылығы
- Банк ісі
- Бизнесті бағалау
- Биология
- Бухгалтерлік іс
- Валеология
- Ветеринария
- География
- Геология, Геофизика, Геодезия
- Дін
- Ет, сүт, шарап өнімдері
- Жалпы тарих
- Жер кадастрі, Жылжымайтын мүлік
- Журналистика
- Информатика
- Кеден ісі
- Маркетинг
- Математика, Геометрия
- Медицина
- Мемлекеттік басқару
- Менеджмент
- Мұнай, Газ
- Мұрағат ісі
- Мәдениеттану
- ОБЖ (Основы безопасности жизнедеятельности)
- Педагогика
- Полиграфия
- Психология
- Салық
- Саясаттану
- Сақтандыру
- Сертификаттау, стандарттау
- Социология, Демография
- Спорт
- Статистика
- Тілтану, Филология
- Тарихи тұлғалар
- Тау-кен ісі
- Транспорт
- Туризм
- Физика
- Философия
- Халықаралық қатынастар
- Химия
- Экология, Қоршаған ортаны қорғау
- Экономика
- Экономикалық география
- Электротехника
- Қазақстан тарихы
- Қаржы
- Құрылыс
- Құқық, Криминалистика
- Әдебиет
- Өнер, музыка
- Өнеркәсіп, Өндіріс
Қазақ тілінде жазылған рефераттар, курстық жұмыстар, дипломдық жұмыстар бойынша біздің қор #1 болып табылады.



Ақпарат
Қосымша
Email: info@stud.kz